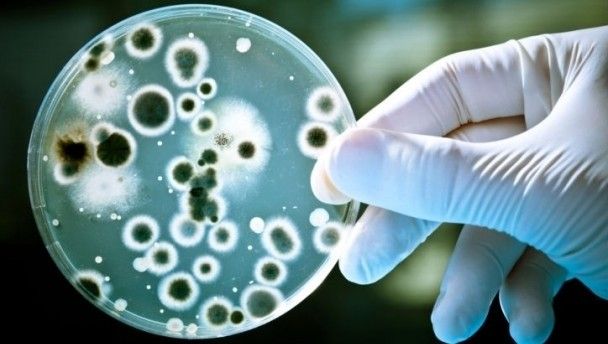

Hitting the gym is not always healthy – here’s JOE’s guide to the diseases that lurk on the exercise machinery and changing room floor.
By Robert Carry
Human papillomavirus
The human papillomavirus, which causes the intermittent outbreak of warts on various parts of the body, is an organism commonly found around even the cleanest of gyms.
If you come into contact with the virus it can remain in your system indefinitely. Although in some patients it never brings about any outward symptoms, others end up breaking out in single or clusters of warts.
The warts are sometimes treatable with a topical cream but can need to be frozen off by a doctor. Alarmingly, once you contract the papillomavirus it remains in your system and can trigger regular outbreaks for years to come.
Verrucas
Otherwise known as a plantar wart, verrucas are also the result of our friend the human papillomavirus. When the soles of the foot come into contact with the virus it can trigger painful, boil-like warts to emerge, generally on an area of the foot that comes under pressure.
Plantar warts are notoriously difficult to treat. Topical creams are available but their effectiveness is debateable. That said, the warts will generally disappear without treatment. In severe cases, surgery may be required to cut or freeze the warts from the foot.
Athlete’s Foot
Athlete’s foot is one of the most common fungal infections found in humans. It targets the skin between and around the toes causing scaling, flaking and itching in affected areas. The fungi responsible, Trichophyton, is often transferred from foot-to-foot in moist areas where people walk barefoot – so showers and swimming pools are the main culprits.
Although generally confined to the feet it can find it’s way to other parts of your body, most notably, your groin.
Keeping your feet clean, drying them thoroughly and changing your socks regularly can wipe out the fungus. If symptoms persist however, you can hit your pharmacy for any of a number of effective over-the-counter topical treatments.
Ringworm
Ringworm, otherwise known as dermatophytosis, is a fungal infection which affects the skin. It appears as a raised, ring-shaped mark on the surface of the skin and although generally painless, it is unsightly and highly infectious.
It thrives on skin that is warm and moist so gym-fresh bodies are a particularly prone. Its spores can survive outside the body and are frequently found on surfaces in locker rooms, tanning beds swimming pools.
The fungi may be present without any symptoms and one in five adults are believed to be carriers. Topical antifungal treatments such as Miconazole or Terbinafine are successful in treating the condition and marks will normally disappear within two or three weeks.
Also, people who suffer an outbreak should avoid touching the lesions to prevent spreading to other people or parts of the body.
Staph infection
The bacteria staphylococcus, which can cause everything from lesions to food poisoning, is most famous as the antibiotic-resistant MRSA that has been stalking hospitals for 30 years. However, it has now found its way into gyms.
The bacteria commonly spreads between people who come into close contact. This has meant people involved in fight sports such as MMA have proved particularly susceptible.
However, staph doesn’t just transfer via skin-to-skin contact and can spread by shared towels, razors and sports equipment.
The bacteria is most easily transferred via cuts and abrasions on the surface of the skin. It can eat away at the flesh and lead to horrific, gaping wounds. When it’s not stopped, it can cause blood poisoning and death.
When first contracted, it can present as one or several painful red bumps, similar to a boils. If it finds it’s way into a cut, staph will often cause pus to ooze from the wound.
What to do
Your gym may be a festering nest of germs, but you can do plenty to prevent yourself from picking something up.
Wear flip-flops when in the changing rooms or in the shower. This should prevent you from contracting verrucas, warts or athlete’s foot.
Wash and dry your feet thoroughly. The soap will kill bacteria and drying them will deprive the fungus of the dampness it thrives in. If you are already infected with athlete’s foot, try using a blow-dryer between your toes. Sounds crazy, but this is the equivalent of deploying a scorched earth policy against the critters.
Use antifungal powder. Sprinkling this stuff into your gym shoes will kill off any latent spores hanging around waiting to burrow between your toes.
Don’t use a towel you’ve just dropped on the locker room floor. If it’s picked up a fungus, virus or bacteria, you certainly don’t want to be dabbing the various sensitive parts of your body dry with it.
Cover cuts. If skin is broken on any part of your body, make sure to cover it up with a water-proof plaster. Use an antibacterial solution on the area around the wound before and after your trip to the gym. This will prevent the dreaded staph from creeping in.
If you’re a regular on the free weights use gloves. Germs can creep in through those nasty calluses that appear on your palms.
Wash straight after training. The longer bugs are on the surface of your skin, the longer they have to make themselves at home.
Use a rash guard. If you’re involved in MMA or another sport that involves a lot of contact with others, these long-sleeved wonders will help stop you picking something nasty up.
LISTEN: You Must Be Jokin’ podcast – listen to the latest episode now!